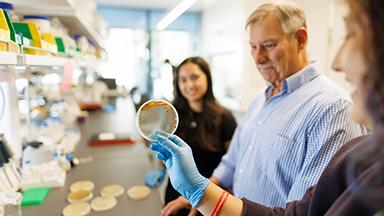
Student Kaitlyn Calligan holds an ancient bacteria strain grown in a petri dish, with student Safiya Rufino and professor emeritus Raul Cano in the background.

News
California Impact
Cal Poly Scientists Look to Ancient Microbes to Discover the Antibiotics of the Future
A quest to discover new antibiotics is taking a Cal Poly biochemistry research team back in time millions of years as they study ancient microorganisms. Research led by biochemistry professor Katharine Watts and Rachel Johnson, a Frost teacher-scholar postdoctoral fellow, involves intensive study of a library of ancient microbial strains that are approximately 25 million to 40 million years old. Professor emeritus Raul Cano, a renowned microbiologist, who once worked with the scientist who inspired Michael Crichton’s 1990 novel “Jurassic Park” novel, donated his collection of 93 prehistoric bacteria strains to Watts for research.
Campus and Community
Cal Poly Celebrates Groundbreaking of Lynda and Stewart Resnick Student Success Center

Cal Poly celebrated the groundbreaking of the Lynda and Stewart Resnick Student Success Center on Nov. 13, marking the start of construction on a transformative facility designed to expand student support and connect students to the resources they need to thrive. Located at the corner of North Perimeter Road and Village Drive, the 36,000-square-foot, three-story facility will be named after global philanthropists and entrepreneurs Lynda and Stewart Resnick, co-owners of The Wonderful Company. The naming honors The Wonderful Company’s $20 million lead gift to the center and the Resnicks’ decades-long commitment to empowering students through education in California’s Central Valley.
Learn More About the Success Center
Science and Technology
Cal Poly to Open Advanced AI Factory with NVIDIA Technology

Cal Poly is launching a new Artificial Intelligence (AI) Factory that will give students and faculty the power to develop and train advanced AI models on site, while offering regional partners a way to tap into high-performance computing resources to tackle pressing challenges in industry and the community. Powered by an NVIDIA DGX B200 BasePOD system and funded through a $3 million investment from The Noyce School of Applied Computing, the system will align Cal Poly with the technology used in NVIDIA’s top-tier data centers and is expected to be fully operational by January 2026.
Learn More About the AI Factory
International Center
Cal Poly Again Ranks No. 1 in Nation for Study Abroad Among Peer Institutions

Cal Poly has earned the nation’s top ranking for study abroad participation among master’s-level institutions for the third consecutive year and fourth overall, according to the Institute of International Education’s Open Doors Report. Announced Nov. 17 to launch International Education Week (IEW), the recognition underscores the university’s excellence in global experiential learning. Open Doors reports 1,188 students studying abroad in 2023-24, with the International Center reporting more than 1,250 total student experiences in 37 countries, led by Spain and Italy. Cal Poly also ranked among the top institutions for long-, mid- and short-term programs. IEW events continue through Nov. 21.
Faculty and Staff
Academic Affairs
Nominate Faculty for the Distinguished Scholarship Award by Nov. 21
Nominations are open through 5 p.m. Friday, Nov. 21, for Cal Poly’s 2025–26 Distinguished Scholarship Award, honoring faculty with exceptional achievements in scholarship or creative activity. Faculty, students, staff and alumni are invited to submit nominations using the online form.
Bailey College of Science and Mathematics
Statistics Consulting Available During Winter Quarter

The Statistics Department is offering statistical consulting service to the university community to facilitate research design and data analysis in a wide variety of disciplines during winter quarter by appointment only. Statistics Professor Soma Roy and Heather Smith will serve as consultants available to advise on data collection, experimental design and analysis of research projects. In addition, Roy is available to lead seminars or tutorials on requested topics and offer advice on various computer packages available at Cal Poly. For more info, visit the Statistics Department website. To schedule a consultation, email statconsulting@calpoly.edu.
Campus Announcements
Office of the Provost
AI Convening Recordings and Resources now Available

Recordings from Cal Poly’s inaugural AI Convening, hosted by the Office of the Provost and the Noyce School of Applied Computing, are now available on the AI Convening website. The event brought together faculty and staff to explore practical and responsible uses of artificial intelligence in teaching, learning, research and university operations. Presentations, session videos and AI resources are posted online. All materials are open to the campus community and may be shared broadly.
Strategic Enrollment Management
The 2026-28 Cal Poly Catalog is Now Available
The Cal Poly Catalog is the official listing of academic programs and courses offered by the university, and the 2026-28 Cal Poly Catalog (effective fall 2026 through summer 2028), is live. In addition to courses, the catalog includes student-related academic policy and provides information on student services. (Please note: To view previous catalogs, simply select “Prior Catalogs” from the navigation menu).
Strategic Enrollment Management
GE 2026 Explained
As of Fall 2026, Cal Poly will transition to the new General Education 2026 template known as GE 2026. The CSU, UC and California Community College systems are realigning their General Education patterns to ensure a single, uniform GE pattern throughout California. The new General Education pattern will apply only to students following degree requirements for the 2026-28 Cal Poly catalog or later catalogs. To assist with this transition, the Office of the Registrar has created a GE 2026 Comprehensive Guide. The guide contains detailed information about changes to General Education areas and individual General Education courses.
Kennedy Library
Participate in Cal Poly’s Artificial Intelligence (AI) Study

The Cal Poly campuses, in coordination with Ithaka S+R, are conducting a study of AI literacy among undergraduate students. We are interviewing instructors to gain a better understanding of their experiences using or teaching with AI tools, their understanding of AI literacy, and the kinds of support or guidance they think would be most helpful. Participation will include a one-hour teleconference (Zoom) interview. If you have questions, please email Foundational Learning and Engagement Librarian Mercedes Rutherford-Patten at meruther@calpoly.edu.
Events
Performing Arts Center
‘Kinky Boots’ Struts into SLO Dec. 1 and 2

Cal Poly Arts presents hit Broadway musical “Kinky Boots,” at 7:30 p.m. Dec. 1 and 2 in the Performing Arts Center’s Harold Miossi Hall. Winner of the Tony, Grammy and London’s Olivier Award, “Kinky Boots” captivates and entertains audiences with a Tony-winning score by Cyndi Lauper, book by four-time Tony Award-winner Harvey Fierstein and original direction and Tony-winning choreography by Jerry Mitchell. Based on true events, “Kinky Boots” follows the journey of an unlikely pair who discovers that you change the world when you change your mind. This event has a 20-percent staff and faculty discount available.
Office of the President
Celebrate the Season
Please join President Jeffrey D. Armstrong and Mrs. Sharon D. Armstrong for our annual holiday reception. It’s an opportunity to connect with coworkers, give back to the community and enjoy this festive time of year.
-
Thursday, Dec. 4 from 3 to 5 p.m.
-
JUSTIN & J. LOHR Center for Wine & Viticulture
-
Building 156
Guests are invited to provide donations to the Cal Poly Food Pantry. Please contact the Office of the President at (805) 756-6000 or presidentsevents@calpoly.edu with any questions or requests for accommodations. We look forward to seeing you. Happy Holidays!
Orfalea College of Business
Attend a Masterclass with Bank of America Technology Executive
Craig Froelich, chief technology officer for Bank of America, will be featured in an Executive Masterclass with Dean Damon Fleming of the Orfalea College of Business. The event will be hosted in Building 3, Room 213 (“The Silo”) from 11 a.m. to noon Thursday, Dec. 4. During the fireside chat, Froelich will share his career journey and his current role at Bank of America; key lessons he has learned for preparing for the current workforce needs, including AI demands; and his experience advocating for neurodiversity at Bank of America. This event is free.
Performing Arts Center
Celebrate the Holidays with Ben Folds Dec. 6

Cal Poly Arts presents “Tis the Season with Ben Folds” at 7:30 p.m. Saturday, Dec. 6, at the Performing Arts Center’s Harold Miossi Hall. The Emmy-nominated singer-songwriter will capture the spirit of the season in a delightful mix of reimagined holiday classics and introspective originals. Celebrated for his work with Ben Folds Five and as a solo artist, Folds served as the first Artistic Advisor to the National Symphony Orchestra at the Kennedy Center, shaping innovative performances over his eight-year tenure. Folds tours globally, performing solo and with top orchestras and composes for film, TV and theatre.
Athletics
Friday, Nov. 21
-
Women’s basketball vs. Southern Utah, Mott Athletics Center, 6 p.m.
Saturday, Nov. 22
-
Football vs. Eastern Washington, Mustang Memorial Field, 2 p.m.
Employment Opportunities
CSU/State Positions
The official listing of staff and management vacancies is posted on jobs.calpoly.edu. As a courtesy to our on-campus employees, job vacancies are also published in the Cal Poly Report. Current employees can also find job postings at CSU Careers, an internal job site for CSU employees. To apply, go online and complete the application form. Applicants needing assistance may contact Human Resources at (805) 756-2236.
For assistance with academic positions, email Academic Personnel.
Submit all requested application materials as attachments to your online application by the review begin date for full consideration.
- Police Lieutenant – Administration and Finance – AFD-Public Safety. Anticipated hiring range: $150,000 - $170,000. Open until filled. #552018
- Assessment and Curriculum Coordinator - Academic Programs and Planning (Administrative Support Coordinator II) – Academic Affairs-Provost – AA-AIP-Pgms & Planning. $52,404 - $76,344 per year. Anticipated hiring range: $54,516- $66,456 Per Year. Open until filled. #552151
- Lead Laborer - Facilities Management and Development – Administration and Finance – FacMD-Facilities Support Svcs. $44,160 - $57,024 per year. Anticipated hiring range: $46,000 - $60,000 per year. Open until filled. #551619
- Associate Director of Donor Stewardship (Administrator I) - Univ Development & Alumni Eng – UDAE-Donor Relations. Anticipated hiring range: $70,000 - $90,000. Open until filled. #552877
- Waterfront Manager - Solano Campus (Administrator II) - Academic Affairs-Provost – AA-MP-Waterfront. Anticipated hiring range: $112,000 - $130,000 per year. Open until filled. #553141
- Assistant Professor of Music - Musicology/Music History (AY 26/27) CLA-Music - #552292
- Assistant Professor of Accounting - OCOB-Accounting - #552892
- Assistant Professor of Business Law - OCOB-Accounting #552863
- Assistant Professor of Marketing OCOB-Marketing - #552881
- Assistant Professor of Marketing (Sales) - OCOB-Marketing #552876
- Assistant Professor of Economics - OCOB-Economics #552528
- Assistant Professor of Management/Organizational Behavior, OCOB-Mgmt, HR & Info Sys Area - #552754
- Assistant Professor of Finance, OCOB-Mgmt, HR & Info Sys Area - #552931
- Assistant/Associate Professor of Organizational Behavior/HR Management OCOB-Mgmt, HR & Info Sys Area - #552650
- Assistant Professor of Information Systems, OCOB-Mgmt, HR & Info Sys Area - #552729
- Assistant Professor of English - Creative Writing and Latinx/e Literature (26/27) CLA-English - #552462
- Assistant Professor in Graphic Communication - Expertise in Sales/Marketing, Operations & Strategic Management (26/27) - CLA-Graphic Communication- #552104
- Assistant/Associate Professor, Marine Transportation - CAFES-Marine Transportation #552922
- Assistant/Associate Professor, Agricultural Education CAFES-AgEd & Communication - #552875
- Assistant Professor - Materials Engineering (AY 26/27) - CENG-Materials Engineering #552609
- Full Time Lecturer of Management/HR 2+2 AHC - OCOB-Mgmt, HR & Info Sys Area #552505
- Assistant Professor in Feminist/ Queer Science & Technology Studies (STS) (26/27)- CLA- Women/Gender/Queer Studies - #552430
PART-TIME LECTURER POOLS – Pools are now open for 2025-2026 academic year. Please visit jobs.calpoly.edu and search department of interest.
Submission Guidelines
Cal Poly Report (CPR) is Cal Poly's official employee newsletter, designed to communicate information about officially sanctioned university news or events to faculty, staff and administrators.
All announcements, events and other listings and information must be faculty- and/or staff-focused. Submissions may run only one time — with the exception of Catastrophic Leave announcements and Employment Opportunities, which can run up to two consecutive weeks. Items are strictly limited to 100 words and should, whenever possible, provide a link to additional information online.
To help ensure CPR continues to contain only relevant and approved information, submissions are required to come from or be approved by the employee designated to approve submissions in the respective colleges, units and work areas. Entries submitted by those other than the designated approver must be accompanied by an approval form signed by the unit's approver. CPR is published on Wednesdays weekly during the school year, except during academic breaks, and monthly in the summer. The deadline for each issue is 5 p.m. the Thursday prior to publication.
Event Marketing Resources
University Communications and Marketing has resources and tools to help promote your event to the campus community.
University Events Calendar
University Events Calendar is a Master Calendar that lists all events — such as performances, lectures, workshops and more.
25Live: Space and Event Scheduling
Use 25Live to help you schedule or book a venue for an upcoming on-campus event. Note that a minimum three-day lead time is required to process a request for use of space through the Office of the Registrar.
Cal Poly Now
Turn to Cal Poly Now for Student Affairs events, learning opportunities and more. Find the latest student-focused campus events from your favorite Student Affairs programs and services by through Cal Poly Now.
Thank you for reading the Cal Poly Report.
The next issue will be Wednesday, November 26.
